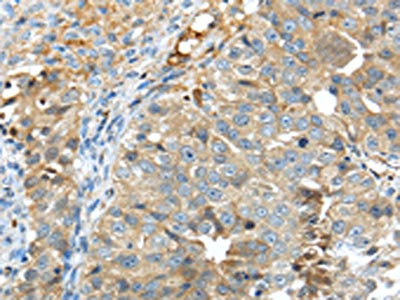

TNIP1 Antibody
-
中文名稱:TNIP1兔多克隆抗體
-
貨號:CSB-PA969029
-
規格:¥1100
-
圖片:
-
The image on the left is immunohistochemistry of paraffin-embedded Human breast cancer tissue using CSB-PA969029(TNIP1 Antibody) at dilution 1/40, on the right is treated with synthetic peptide. (Original magnification: ×200)
-
The image on the left is immunohistochemistry of paraffin-embedded Human thyroid cancer tissue using CSB-PA969029(TNIP1 Antibody) at dilution 1/40, on the right is treated with synthetic peptide. (Original magnification: ×200)
-
Gel: 8%SDS-PAGE,Lysate: 40 μg,,Primary antibody: CSB-PA969029(TNIP1 Antibody) at dilution 1/400 dilution,Secondary antibody: Goat anti rabbit IgG at 1/8000 dilution,Exposure time: 20 seconds
-
-
其他:
產品詳情
-
Uniprot No.:
-
基因名:TNIP1
-
別名:ABIN 1 antibody; HIV-1 Nef-interacting protein antibody; hVAN antibody; KIAA0113 antibody; Naf1 antibody; Nef-associated factor 1 antibody; Nip40-1 antibody; TNFAIP3 interacting protein 1 antibody; TNFAIP3-interacting protein 1 antibody; TNIP-1 antibody; Tnip1 antibody; TNIP1_HUMAN antibody; VAN antibody; Virion-associated nuclear shuttling protein antibody
-
宿主:Rabbit
-
反應種屬:Human
-
免疫原:Synthetic peptide of Human TNIP1
-
免疫原種屬:Homo sapiens (Human)
-
標記方式:Non-conjugated
-
抗體亞型:IgG
-
純化方式:Antigen affinity purification
-
濃度:It differs from different batches. Please contact us to confirm it.
-
保存緩沖液:-20°C, pH7.4 PBS, 0.05% NaN3, 40% Glycerol
-
產品提供形式:Liquid
-
應用范圍:ELISA,WB,IHC
-
推薦稀釋比:
Application Recommended Dilution ELISA 1:2000-1:5000 WB 1:500-1:2000 IHC 1:25-1:100 -
Protocols:
-
儲存條件:Upon receipt, store at -20°C or -80°C. Avoid repeated freeze.
-
貨期:Basically, we can dispatch the products out in 1-3 working days after receiving your orders. Delivery time maybe differs from different purchasing way or location, please kindly consult your local distributors for specific delivery time.
-
用途:For Research Use Only. Not for use in diagnostic or therapeutic procedures.
相關產品
靶點詳情
-
功能:Inhibits NF-kappa-B activation and TNF-induced NF-kappa-B-dependent gene expression by regulating A20/TNFAIP3-mediated deubiquitination of IKBKG; proposed to link A20/TNFAIP3 to ubiquitinated IKBKG. Involved in regulation of EGF-induced ERK1/ERK2 signaling pathway; blocks MAPK3/MAPK1 nuclear translocation and MAPK1-dependent transcription. Increases cell surface CD4(T4) antigen expression. Involved in the anti-inflammatory response of macrophages and positively regulates TLR-induced activation of CEBPB. Involved in the prevention of autoimmunity; this function implicates binding to polyubiquitin. Involved in leukocyte integrin activation during inflammation; this function is mediated by association with SELPLG and dependent on phosphorylation by SRC-family kinases. Interacts with HIV-1 matrix protein and is packaged into virions and overexpression can inhibit viral replication. May regulate matrix nuclear localization, both nuclear import of PIC (Preintegration complex) and export of GAG polyprotein and viral genomic RNA during virion production. In case of infection, promotes association of IKBKG with Shigella flexneri E3 ubiquitin-protein ligase ipah9.8 p which in turn promotes polyubiquitination of IKBKG leading to its proteasome-dependent degradation and thus is perturbing NF-kappa-B activation during bacterial infection.
-
基因功能參考文獻:
- this review discusses the role of TNIP1 in autoimmune diseases as a regulator of Toll-like receptor signaling PMID: 30402506
- Results showed that ABIN1 acted as a modulator to down-regulate HDAC1 ubiquitination via three different sites, thereby stabilizing HDAC1 by inhibiting its lysosomal and proteasomal degradation. PMID: 29058807
- Results provide evidence that TNIP1 SNP (rs7708392) might be associated with the development of lupus nephritis in Egyptian SLE patients. PMID: 29589214
- cell viability and apoptosis in the hepatic cell line L02 were detected after hypoxia/reoxygenation (H/R) treatment, and MTT assay showed that cell viability was inhibited after H/R treatment, but reversed after TNIP1 transfection PMID: 29709475
- association of TNIP1 was stronger in AIH without HLA-DRB1*04:05 allele (P = 0.0063, Q = 0.0127, OR 1.48, 95% CI: 1.12-1.96), though the association was not detected in AIH with DRB1*04:05 PMID: 29559739
- Naf1 contributes to the maintenance of HIV-1 latency by inhibiting long terminal repeat driven HIV-1 gene transcription in a nuclear factor kappa B-dependent manner. PMID: 27795436
- the risk allele for the TNIP1 rs7708392 polymorphism was associated with systemic lupus erythematosus susceptibility. PMID: 29783072
- C/EBP beta LAP isoform expression was increased and LIP/TNFAIP3/TNIP1 expression was decreased in systemic lupus erythematosus (SLE) patients. LAP expression was positively correlated with SLE disease activity; TNFAIP3 and TNIP1 expression was negatively correlated with SLE disease activity. PMID: 27659348
- genetic variation in TNIP1 gene is associated with gastric carcinoma PMID: 27250029
- An association of the GPX3-TNIP1 locus with ALS is identified using cross-ethnic meta-analyses. [Meta-Analysis] PMID: 28931804
- These studies define a novel role for ABIN1 dysfunction and NF-kappaB in mediating glomerulonephritis through proinflammatory activation of podocytes. PMID: 28935578
- IM could upregulate A20 protein to inhibit the activation of NF-kappaB pathway in Jurkat T cells, which was independent of the ABIN1 protein. PMID: 28502291
- LILRB1 ligation during monocyte differentiation to dendritic cells in vitro increases ABIN1 expression. Increased ABIN1 expression occurs in "immunosuppressive" monocytes of patients with non-Hodgkin lymphoma ex vivo. ABIN1 siRNA allows dendritic cells and immunosuppressive monocytes to respond to stimulation by allowing NF-kappaB translocation to the nucleus, more phagocytosis, cytokine secretion, and T-cell stimulation. PMID: 27129285
- These findings show ABIN1 as an intrinsic suppressor of HIV-1 mRNA transcription by regulating the ubiquitination of Tat. PMID: 28193275
- Polymorphisms in TNIP1 are associated with GPP in Chinese Han population. However, no association with PPP was found. These findings suggest that TNIP1 might be a susceptibility gene for GPP. PMID: 27364786
- The findings of this study suggested that TNIP1 is a new potential predisposing gene to spina bifida (SB) and its pathway needs to be investigated in human NTD in order to confirm its role and to plan appropriate counseling to families PMID: 27125519
- Data suggest that reduced TNFalpha-induced protein 3-interacting protein 1 (TNIP1) expression may have a role in the pathogenesis of myasthenia gravis (MG)for patients with thymoma. PMID: 27577206
- HIV-1 depends on host-cell-encoded factors to complete its life cycle; data suggest that nucleus-located NAF1/TNIP1 promotes nuclear export of un-spliced HIV-1 gag mRNA; association between NAF1/TNIP1 and CRM1 is required for this function. PMID: 26733199
- Hepatitis C virus antigen stimulation up-regulates A20/A20-binding inhibitor of NF-kappaB binding protein expression, which consequently contributes to inefficient M1 macrophage polarization. PMID: 26382585
- Data suggest that tumour necrosis factor alpha-induced protein 3 (TNFAIP3) and TNFAIP3-interacting protein 1 (TNIP1) single nucleotide polymorphisms (SNPs) confer increased risk of psoriasis in ethnic South Indian Tamils. PMID: 26738398
- Since TNIP1 may facilitate the function of TNFAIP3 in the negative feedback regulation of NF-kappaB activation [5], the corresponding transcript levels of TNIP1 in psoriasis vul- garis were investigated in this study. PMID: 25631139
- The aim of this study was to investigate whether the HCP5, TNIP1, TNFAIP3, SPATA2 and COG6 genes were genetic risk factors for psoriasis in Chinese population. PMID: 25264125
- Single-nucleotide polymorphisms rs7708392 and rs495881 in TNIP1 were significantly associated with Lupus Nephritis in individuals with European or African ancestry. PMID: 25034154
- HSPA6 regulation by TNIP1 occurs in promoter regions lacking binding sites for known TNIP1-repressed transcription factors PMID: 25447897
- Report role of TNIP1 genetic variants in confering risk of systemic lupus erythematosus in Chinese population. PMID: 24091983
- TNIP1 polymorphism may be a risk factor for VKH syndrome in Han Chinese PMID: 24788730
- Analysis of SNP in the TNIP1 gene and expression of this gene in peripheral blood lymphocytes indicated these SNP were associated with the occurrence of systemic lupus erythematosus in Han Chinese patients. PMID: 23858047
- We conclude that polymorphisms in TNIP1 are associated with antibody-positive primary Sjogren's syndrome. PMID: 23944604
- variants in the TNIP1 gene are associated with the risk for lupus nephritis and could be mechanistically involved in disease development via aberrant regulation of NF-kappaB and mitogen-activated protein kinase activity. PMID: 23970121
- TNIP1/ANXA6 and CSMD1 variants interacting with cigarette smoking and alcohol intake affect risk of psoriasis. PMID: 23541940
- Data indicate significant multiplicative interaction observed between NFKB1 rs28362491 and TNIP1 rs3792783 in systemic lupus erythematosus. PMID: 23911423
- Analysis of the TNIP1 promoter reveals multiple transcription start sites in its GC-rich proximal regions along with two transcriptionally active specificity protein (SP) sites, responsive to both Sp1 and Sp3. PMID: 23464785
- These data confirmed the influence of TNIP1 on an increased susceptibility to systemic sclerosis and reinforced this locus as a common autoimmunity risk factor. PMID: 22896740
- This study demonistrated that (151) Pro-->Ala change in TNIP1 association to myasthenia gravis. PMID: 23055271
- Our results confirm the association signals between systemic lupus erythematosus and TNIP1 variants in multiple populations and provide new insight into the mechanism by which TNIP1 variants may contribute to SLE pathogenesis. PMID: 22833143
- Data indicate that TNFAIP3, ETS1 and TNIP1 are probably common susceptibility genes for systemic lupus erythematosus (SLE) in Chinese populations, and they may contribute to the pathogenesis of multiple SLE subphenotypes. PMID: 22087647
- we integrate the current knowledge of TNIP1s functions with the diseases in which it has been associated to potentially elucidate the role this regulator has in promoting or alleviating these inflammatory diseases[review] PMID: 22542476
- The TNIP1 distal promoter, approximately 4600 nucleotides upstream of a frequently utilized transcription start site region, contains PPAR-gamma and NF-kappaB sites that bind the respective transcription factors in vivo. PMID: 22001530
- recombinant transgene facilitates the transcription of pro-inflammatory cytokines in fibroblast-like synoviocytes in rheumatoid arthritis PMID: 22093807
- A markedly reduced expression of the TNIP1 gene and also its protein product were observed both in lesional skin tissue and in cultured dermal fibroblasts from SSc(Systemic sclerosis) patients. PMID: 21750679
- The requirements for TNIP1-peroxisome proliferator activated receptor (PPAR) interaction are characteristic for coactivators; however, TNIP1 partially decreases PPAR activity. PMID: 21967852
- The varying levels and distribution of TNIP1 in normal and disease state tissues could be expected to affect processes in which TNIP1 is involved PMID: 22147607
- The researchers found a genotype association of SNP rs1808593 NOS3 polymorphisms and HIE. PMID: 21674837
- ABIN1 requires its ubiquitin binding domain and cooperates with TAX1BP1 and A20 to restrict antiviral signaling. PMID: 21885437
- The IL23A and TNIP1 genes showed convincing evidence for association SNPs mapping to previously reported psoriasis loci show evidence for association to PSA. PMID: 21623003
- the interaction of ABIN1 with polyubiquitin is required to limit the activation of TLR-MyD88 pathways and prevent autoimmunity PMID: 21606507
- A20, ABIN-1/2, and CARD11 mutations have prognostic value in gastrointestinal diffuse large B-cell lymphoma PMID: 21266526
- Association of TNIP1 with systemic lupus erythematosus was confirmed in a Japanese population PMID: 20849588
- Significant associations were found for the single nucleotide polymorphism rs10036748 of TNIP1 with photosensitivity and vasculitis in patients with systemic lupus erythematosus PMID: 20516000
- A new ERK2 binding protein, Naf1, attenuates the EGF/ERK2 nuclear signaling. PMID: 12220502
顯示更多
收起更多
-
亞細胞定位:Cytoplasm. Nucleus. Note=Shuttles between the nucleus and cytoplasm in a CRM1-dependent manner.
-
組織特異性:Ubiquitous. Strongly expressed in peripheral blood lymphocytes, spleen and skeletal muscle, and is weakly expressed in the brain. In peripheral blood mononucleocytes, isoform 4 is mainly expressed and isoform 1 and isoform 7 are almost not expressed. Expr
-
數據庫鏈接:
Most popular with customers
-
-
Phospho-YAP1 (S127) Recombinant Monoclonal Antibody
Applications: ELISA, WB, IHC
Species Reactivity: Human
-
-
-
-
-
-